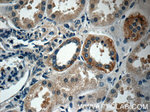
PAAF1 Antibody in Immunohistochemistry (Paraffin) (IHC (P))

Search
Proteintech
PAAF1 Polyclonal Antibody
{{$productOrderCtrl.translations['antibody.pdp.commerceCard.promotion.promotions']}}
{{$productOrderCtrl.translations['antibody.pdp.commerceCard.promotion.viewpromo']}}
{{$productOrderCtrl.translations['antibody.pdp.commerceCard.promotion.promocode']}}: {{promo.promoCode}} {{promo.promoTitle}} {{promo.promoDescription}}. {{$productOrderCtrl.translations['antibody.pdp.commerceCard.promotion.learnmore']}}
产品信息
17650-1-AP
种属反应
宿主/亚型
分类
类型
抗原
偶联物
形式
浓度
规格
纯化类型
保存液
内含物
保存条件
运输条件
产品详细信息
Immunogen sequence: MLVPCFLYS LQNRKPSLYG SLTCQGIGLD GIPEVTASEG FTVNEINKKS IHISCPKENA SSKFLAPYTT FSRIHTKSIT CLDISSRGGL GVSSSTDGTM KIWQASNGEL RRVLEGHVFD VNCCRFFPSG LVVLSGGMDA QLKIWSAEDA SCVVTFKGHK GGILDTAIVD RGRNVVSASR DGTARLWDCG RSACLGVLAD CGSSINGVAV GAADNSINLG SPEQMPSERE VGTEAKMLLL AREDKKLQCL GLQSRQLVFL FIGSDAFNCC TFLSGFLLLA GTQDGNIYQL DVRSPRAPVQ VIHRSGAPVL SLLSVRDGFI ASQGDGSCFI VQQDLDYVTE LTGADCDPVY KVATWEKQIY TCCRDGLVRR YQLSDL (1-375 aa encoded by B C028628)
靶标信息
PAAF1 inhibits proteasome 26S assembly and proteolytic activity by impairing the association of the 19S regulatory complex with the 20S core. In case of HIV-1 infection, recruited by viral Tat to the HIV-1 promoter, where it promotes the recruitment of 19S regulatory complex through dissociation of the proteasome 26S. This presumably promotes provirus transcription efficiency.
仅用于科研。不用于诊断过程。未经明确授权不得转售。
生物信息学
蛋白别名: Proteasomal ATPase-associated factor 1; Protein G-16; unnamed protein product; WD repeat domain 71; WD repeat-containing protein 71
基因别名: PAAF; PAAF1; Rpn14; WDR71
UniProt ID: (Human) Q9BRP4
Entrez Gene ID: (Human) 80227